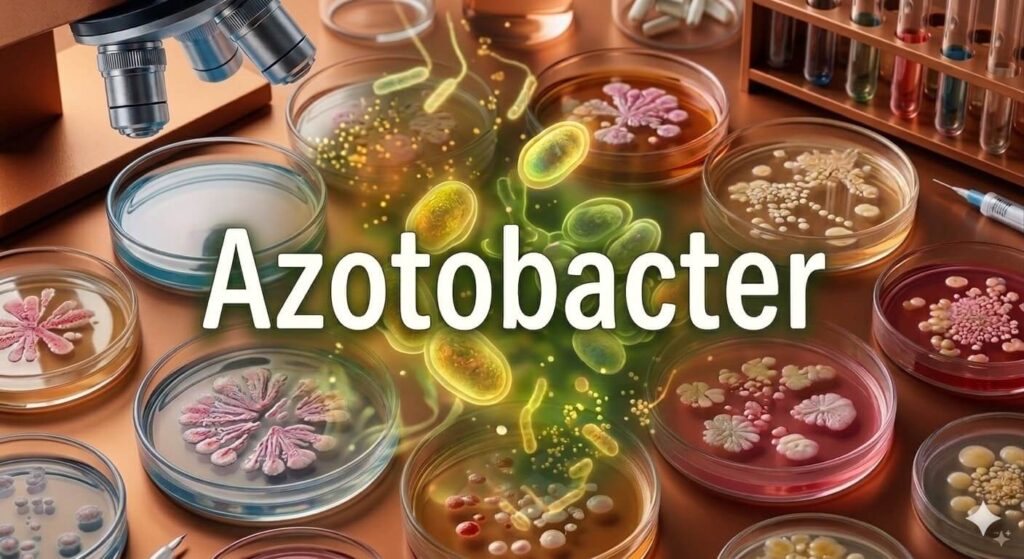
Azotobacter

Azotobacter
If plants could order their meals, nitrogen would always be first on the plate. It’s the nutrient they crave most. The irony is that nitrogen is all around us — it makes up most of the air — yet plants can’t take it in directly. It’s like being surrounded by food locked inside a glass jar. They need a helper to open it.
Nitrogen is the foundation for proteins, DNA, and chlorophyll — the green pigment that lets plants cook their own food through photosynthesis. Without enough nitrogen, plants grow weak, leaves lose their color, and harvests shrink. To be useful, nitrogen gas must be transformed into a plant‑friendly form like ammonia. That’s where soil microbes step in.
Among these helpers, Azotobacter is special. Unlike Rhizobium, which only works in partnership with legumes, Azotobacter is a free‑living bacterium. It doesn’t need a host plant to do its job. It can fix nitrogen independently, making it useful for almost every crop — cereals, vegetables, sugarcane, and more.
Azotobacter thrives in soils that are neutral to slightly alkaline, with enough moisture and organic matter. When conditions are right, it gets to work. Using energy from organic matter, it captures nitrogen gas from the air pockets in soil and converts it into ammonia. This ammonia dissolves into the soil, where plant roots can absorb it directly.
Its secret weapon is an enzyme called nitrogenase. This enzyme can break the tough triple bond that holds nitrogen gas together — one of the strongest bonds in nature. To protect nitrogenase from oxygen (which can damage it), Azotobacter breathes rapidly, using up oxygen around itself. This clever trick allows it to keep fixing nitrogen even in oxygen‑rich soils.
But Azotobacter offers more than nitrogen. It produces natural growth hormones like Indole-3-Acetic Acid (IAA), gibberellins, and cytokinins, which help seeds sprout faster, roots grow deeper, and shoots become stronger. It also makes vitamins that support plant metabolism. On top of that, Azotobacter fights harmful soil fungi by releasing protective substances, giving young roots a safer start. When conditions turn harsh — drought, heat, or poor nutrition — it forms tough‑walled cysts that let it survive until the soil improves. This resilience means Azotobacter can stay alive and active in the soil for a long time.
Farmers today use Azotobacter in simple ways: coating seeds before sowing, mixing it with compost, or applying it as a liquid biofertilizer. Once in the field, it quietly fixes nitrogen, boosts plant growth, and improves soil health. By reducing the need for chemical fertilizers, Azotobacter offers an eco‑friendly path to healthier crops and more sustainable farming.
So the story of Azotobacter is the story of a free‑living friend in the soil. It works independently, feeding plants with nitrogen, protecting them from stress, and keeping the land fertile.